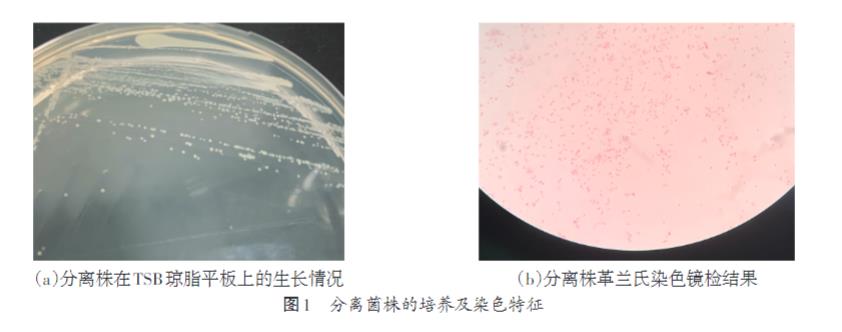
家兔肺支氣管敗血波氏桿菌生長曲線測定及耐藥性研究（一）

m-TiO?/Ag對大腸桿菌和銅綠假單胞菌的抑制作用均隨著銀含量的增大而逐漸增大,且實驗中相同濃度的銀離子對銅綠假單胞菌的抗菌性更強。 ...
歡迎來到BioSense網站!
歡迎來到BioSense網站!

m-TiO?/Ag對大腸桿菌和銅綠假單胞菌的抑制作用均隨著銀含量的增大而逐漸增大,且實驗中相同濃度的銀離子對銅綠假單胞菌的抗菌性更強。 ...

抑菌環法是一種直觀、有效的抗菌性能評價方法,是將過夜培養的待測菌種稀釋至濃度約為1×10?CFU/mL,取100μL均勻涂布在固體平板上,在固體瓊脂平 ...

介孔TiO2(m-TiO2)作為一種新型的納米材料具有良好的親水性、光催化性能和抗菌性,且納米銀也是一種優異的殺菌劑,本研究通過光還原法將二者有效結合 ...

本試驗從死亡家兔肺臟中分離到 1 株支氣管敗血波氏桿菌,測定了該分離株的生長曲線,確定其對數生長期為 2~9 h,處于該時期的細菌活力及致病力均最強。 ...

挑取分離株單個菌落,接種于 5% 血清 TSB 固體培養基上,連續接種兩次。挑取 TSB 培養基上的單菌落接種到 10 mL 的 LB 液體培養基中, ...
試驗所用菌株是從死亡家兔肺組織病料中分離得到,經測序鑒定為支氣管敗血波氏桿菌,試驗對其進行生長曲線測定,以了解其生長規律。同時用分離株測定其對 SPF ...

生長能力測定結果顯示,缺失株Δlmo1508/lmo1509與親本株10403S在BHI培養基中的生長趨勢相似(圖7),表明lmo1508/lmo15 ...

嬰幼兒是侵襲性NTS感染的高發人群。當前NTS耐藥情況比較嚴峻,哌拉西林他唑巴坦可能是治療兒童多重耐藥NTS感染的有效選擇,而硝基呋喃類抗菌藥物可能也 ...

利用生物信息學分析獲得gsh-px基因上游的啟動子序列,以10403S基因組和質粒pFL251為模板分別擴增出508 bp的gsh-px啟動子Pgsh ...

分別從親本株10403S、缺失株Δlmo1508/lmo1509的固體平板上挑取單菌落接種于液體BHI中,37 ℃條件下振蕩培養過夜,以1∶100比例 ...